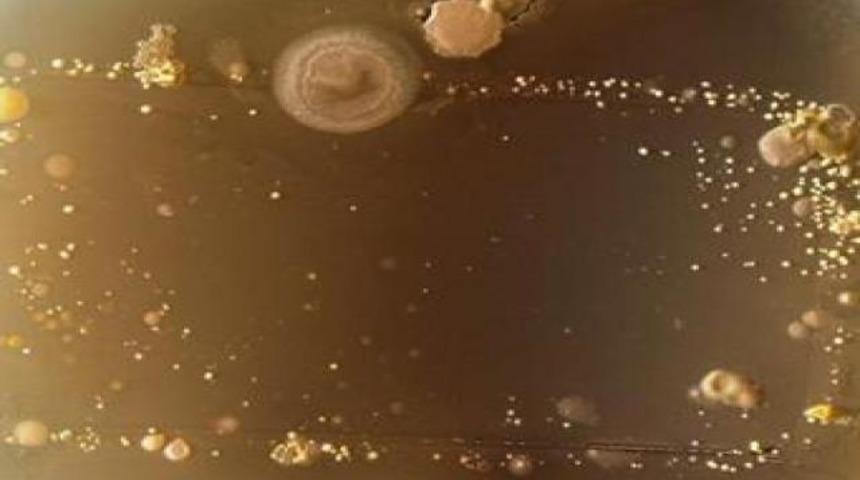
Avucunuzun i&ccedil;indeki gizli tehlike

Akıllı telefonlara yakından bakan bilim adamları bazı bakterilerin yaşadığını farketti.

Sanat çalışması gibi görünen bu fotoğraf aslında bir bakteriye ait.

Bilim adamlarının "akıllı telefon bakterileri" olarak adlandırdığı bu canlılar, bizimle sürekli içiçe.

İngiltere'deki Surrey Üniversitesi Mikrobiyoloji bölümü öğrencileri cep telefonlarına yakından bakmaya karar verince bakterileri farkettiler.

İnanması zor ama cep telefonlarında tuvaletin 18 katı daha fazla bakteri bulundu.

Öğrenciler, bakterileri laboratuvarlarda ürettiler ve geliştirdiler. Cep telefonunu bakteri üretme kaplarına koyan öğrenciler, 3 gün sonra bu garip yaratıkları görüntülediler.

Üniversiteden Doktor Simon Park, cep telefonlarının sadece iletişim aracı olmadığını, bizim kişisel izlerimizi de taşıdığını söylüyor. Tabi aynı zamanda yediklerimizi, içtiklerimizi de telefonlara bir şekilde bulaştırıyoruz.

Üniversitede süren çalışmalar sırasında bakteriler fotoğraflandı ve bu görüntüler büyütüldü.

Bu bakteriler tümü, iğrenç görünmelerine karşın zararlı değil. Ancak, Staphylococcus aureusgibi tehlikeli bazı bakteriler de telefonlarda görülebiliyor. Bu bakteri, "Hastane infeksiyonu" olarak adlandırılıyor. Akıllı telefonların klavye ve benzeri bir dizi tuşa sahip olması, daha çok bakteri taşımalarına neden oluyor. Eski tip telefonlar bu nedenle daha az pis olabilir.

Bu bakterilerden kurtulmanın yolu var mı?

En iyi yöntem telefonları temiz tutmak ve mümkün olduğu kadar sık silmek.

Uzmanlar, ıslak mendillerin kullanılmasını öneriyor. Cep telefonlarına bakteri bulaştırmamanın yollarından birisi de, tuvalete giderken, telefonu dışarda bırakmak. Bakterilerin çoğu elden telefonlara geçtiği için, ellerin temizliği, telefona yabancı kişilerin dokunmamasına izin vermemek de çözüm olabilir.